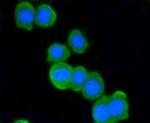
ATM Antibody in Immunocytochemistry (ICC/IF)

Search
Invitrogen
ATM Recombinant Rabbit Monoclonal Antibody (SI70-01)
{{$productOrderCtrl.translations['antibody.pdp.commerceCard.promotion.promotions']}}
{{$productOrderCtrl.translations['antibody.pdp.commerceCard.promotion.viewpromo']}}
{{$productOrderCtrl.translations['antibody.pdp.commerceCard.promotion.promocode']}}: {{promo.promoCode}} {{promo.promoTitle}} {{promo.promoDescription}}. {{$productOrderCtrl.translations['antibody.pdp.commerceCard.promotion.learnmore']}}
图: 1 / 13
ATM Antibody (MA5-32063) in ICC/IF

Please note: We are reviewing Western blot images included in the antibody testing data in our catalog, including those provided by third parties. Unless expressly labeled or annotated as “raw-unedited”, Western blot images included in the antibody testing data in our catalog may have been edited, optimized or otherwise adjusted for presentation.
产品信息
MA5-32063
种属反应
已发表种属
宿主/亚型
Expression System
分类
类型
克隆号
抗原
偶联物
形式
浓度
规格
纯化类型
保存液
内含物
保存条件
运输条件
RRID
产品详细信息
Recombinant rabbit monoclonal antibodies are produced using in vitro expression systems. The expression systems are developed by cloning in the specific antibody DNA sequences from immunoreactive rabbits. Then, individual clones are screened to select the best candidates for production. The advantages of using recombinant rabbit monoclonal antibodies include: better specificity and sensitivity, lot-to-lot consistency, animal origin-free formulations, and broader immunoreactivity to diverse targets due to larger rabbit immune repertoire.
靶标信息
Ataxia-telangiectasia Mutated (ATM) is a protein that belongs to the PI3/PI4 kinase family. Ataxia-telangiectasia is a rare autosomal recessive disorder characterized by progressive neurologic degeneration, immunologic deficiency, and an increased risk of lymphoid cancer. The ATM gene codes for a protein belonging to the phosphoinositide 3-kinase (PI3K) superfamily. ATM phosphorylates proteins instead of lipid and has many downstream targets that act as cell-cycle regulators including: P53, Mdm2, BRCA1, and SMC1. The ATM protein is responsible for repairing double-stranded DNA breaks that occur because of ionizing radiation and other mutagens. The ATM's C-terminal region has extensive homology to the catalytic domains of phosphatidylinositol 3-kinases (PI3 kinases). Studies have shown that ATM becomes autophosphorylated and upregulated by exposure to ionizing radiation. AT cells are hypersensitive to ionizing radiation, impaired in mediating the inhibition of DNA synthesis and display delays in p53 induction. Further, DNA damage caused by ionizing irradiation activates ATM-kinase, leading to a cascade of kinase reactions that regulate cell cycle, apoptosis, and DNA damage repair. Studies have linked ATM to apoptosis along with Nbs1 and Chk2 in the E2F1 pathway.
仅用于科研。不用于诊断过程。未经明确授权不得转售。
生物信息学
蛋白别名: A-T mutated; AT mutated protein; Ataxia t; Ataxia telangiectasia mutated; DKFZp781A0353; EC 2.7.1.37; MGC74674; Serine-protein kinase ATM
基因别名: ATM
Entrez Gene ID: (Human) 472




